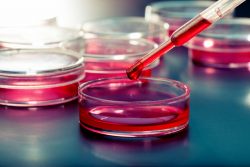
Общий анализ крови кошек

Панкреатит у кошек: симптомы, лечение, диета
Опасное и коварное заболевание кошек — панкреатит или воспаление поджелудочной железы. В нашей статье вы найдете описание симптомов и диагностики, советы по лечению и поддержанию больного животного, а так же рекомендации по лечебному питанию.
Читать далее